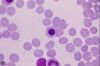

Hematopoiesis and Bone Marrow Histology
|
|
|

Polychromatic erythroblast - histology slide
|
|

Plasmocyte - histology slide
|
|

Plasmoblast - histology slide
|
|
Orthochromatic erythroblast - histology slide
|
|

Orthochromatic erythroblast - histology slide
|
|

Neutrophilic promyelocyte - histology illustration
|
|

Neutrophilic myelocyte - histology illustration
|
|

Neutrophil promyelocyte - histology slide
|
|

Neutrophil myelocyte - histology slide
|
|

Neutrophil myelocyte - histology slide
|
|

Neutrophil metamelocyte - histology slide
|
|

Neutrophil band - histology slide
|
|
|